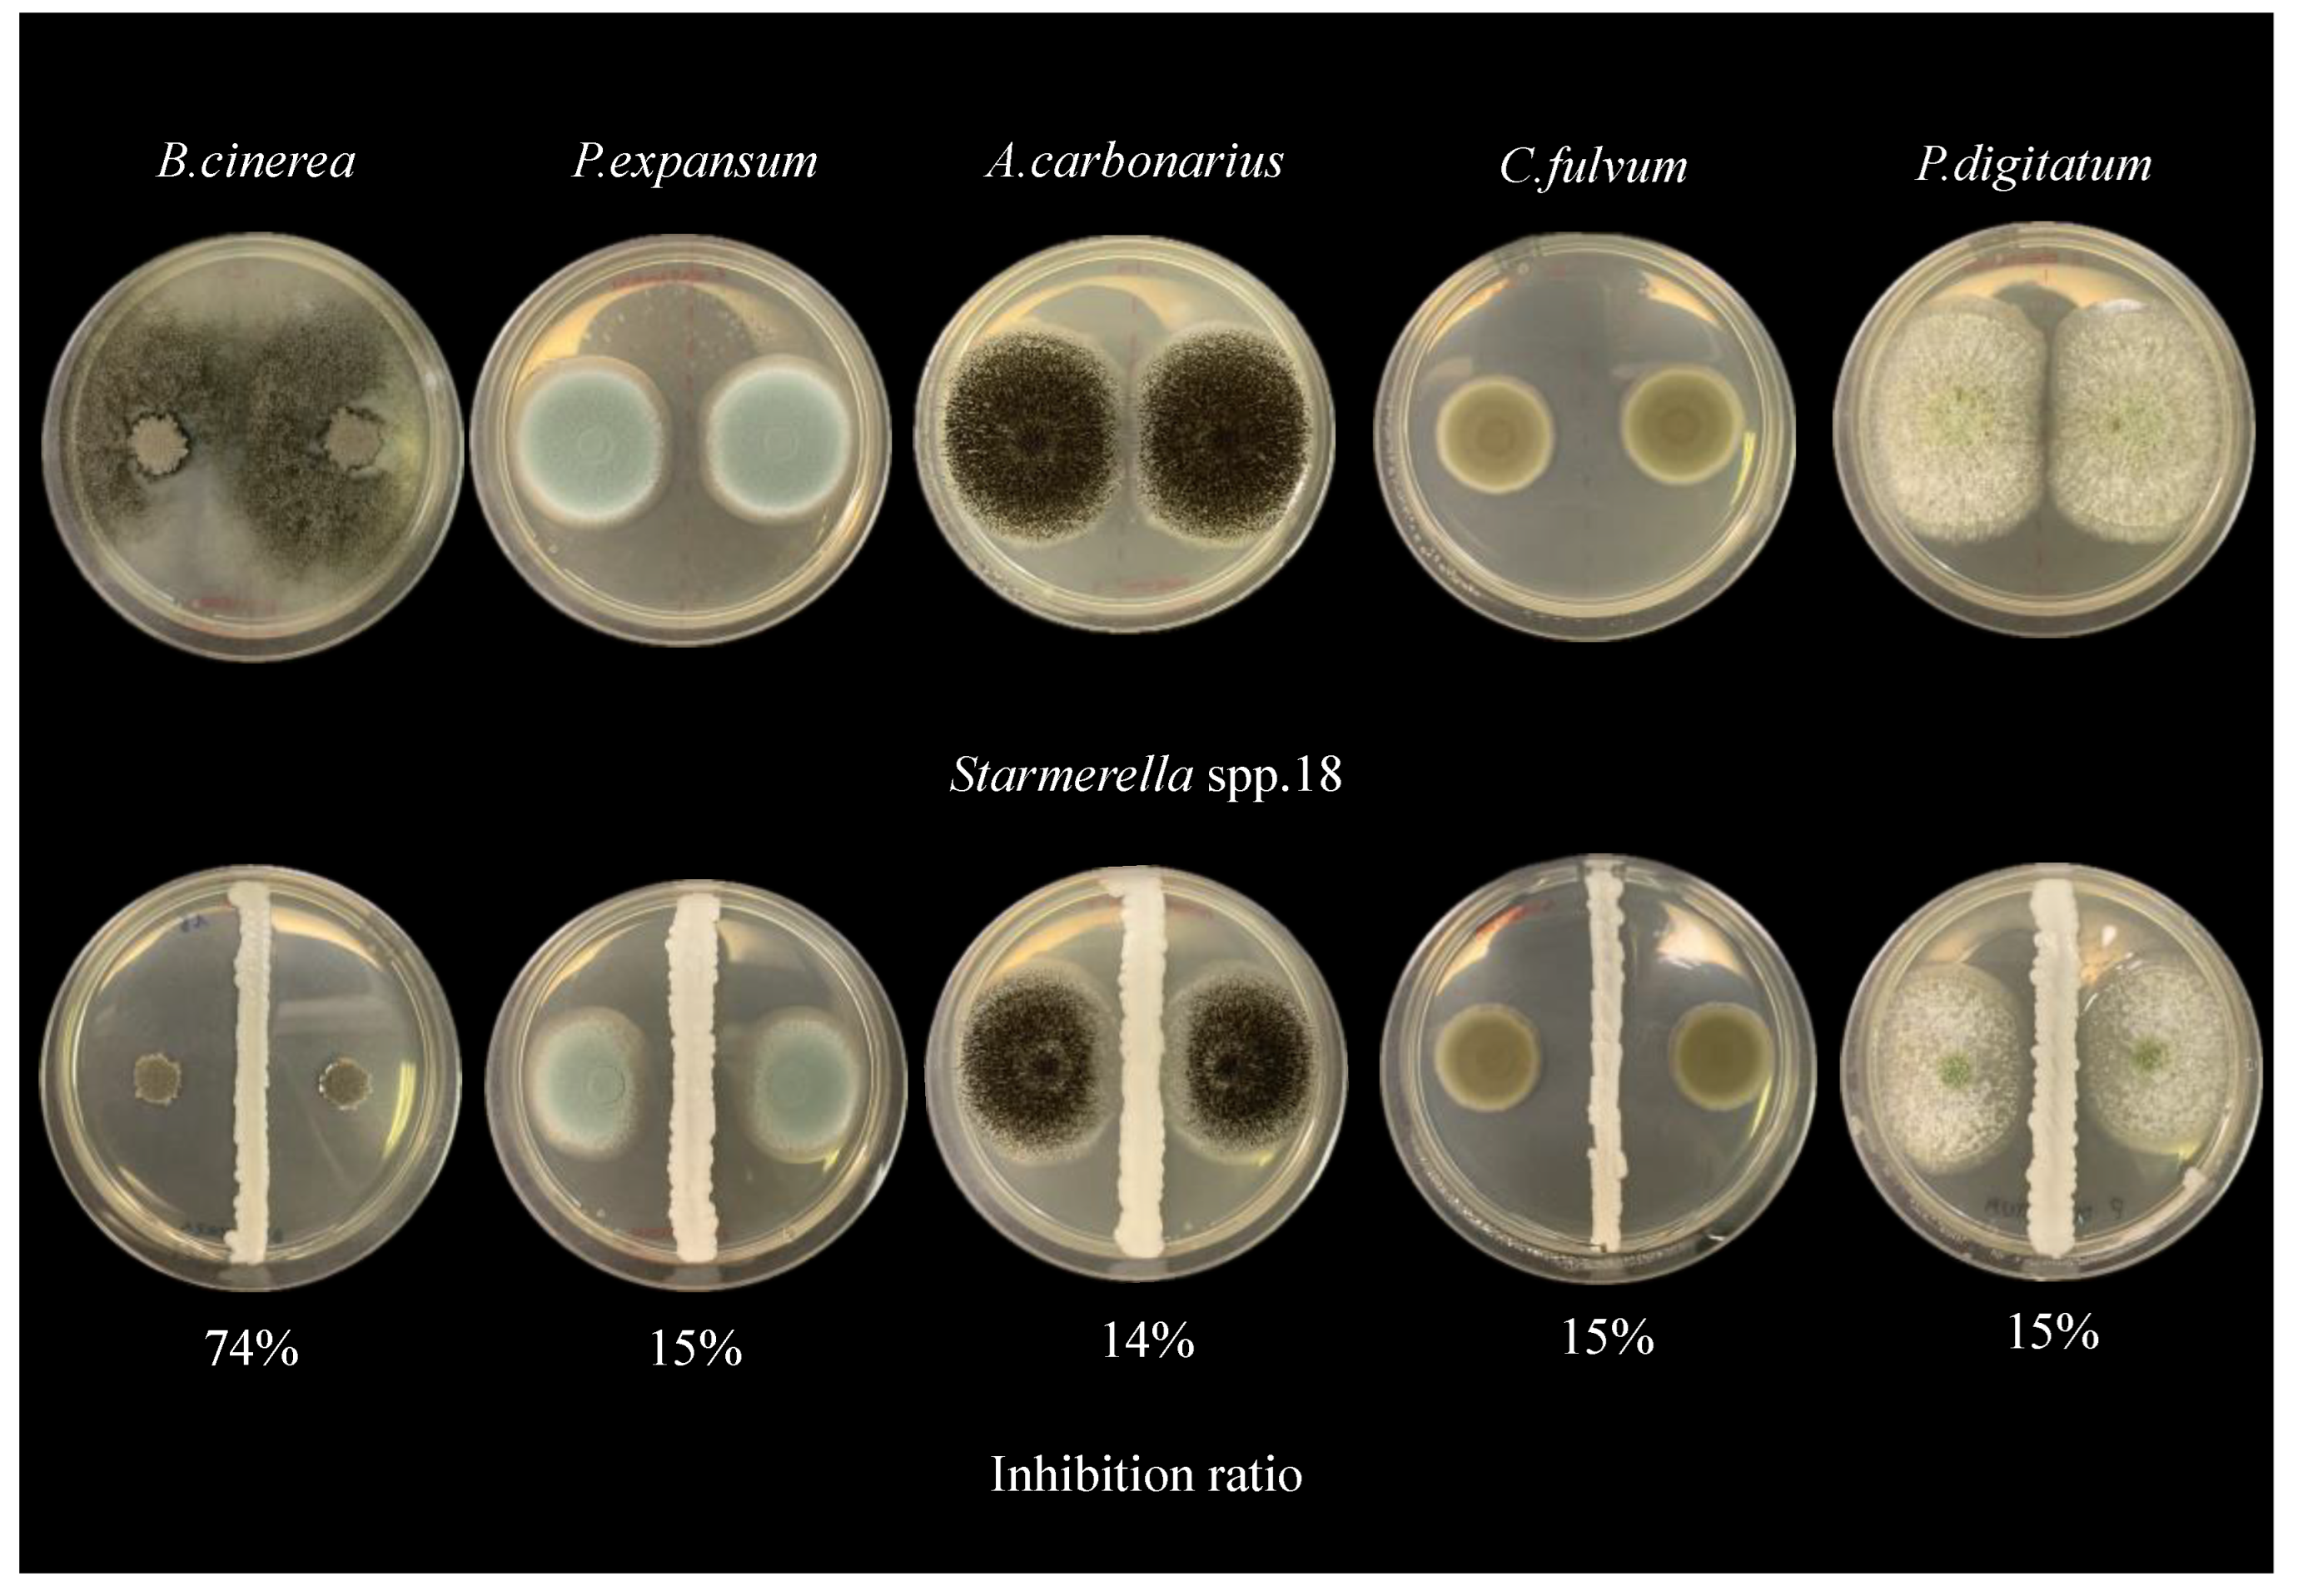
Fermentation 11 00290 g003

From Pollen to Bee Bread: A Reservoir of Functional Yeasts
Abstract
1. Introduction
2. Materials and Methods
2.1. Bee Pollen Collected and Bee Bread Sampling
2.2. Processing of Samples
2.3. Isolation and Identification of Yeasts
2.4. Determination of In Vitro Antioxidant Capacity (DPPH Assay)
2.5. Total Polyphenols and Flavonoids Content
2.6. Antimicrobial Activity
2.7. Phytase Activity
2.8. Preliminary Probiotic Features of Isolated Yeasts
2.9. Statistical Analysis
3. Results
3.1. Yeast, Bacterial, and Mold Occurrence
3.2. Yeast Isolates Identification
3.3. Antioxidant Activity and Total Polyphenols
3.4. Antimicrobial Activity
3.5. Probiotic Features, Phytase Activity, and Safety Tests
4. Discussion
5. Conclusions
Supplementary Materials
Author Contributions
Funding
Institutional Review Board Statement
Informed Consent Statement
Data Availability Statement
Conflicts of Interest
References
- Gilliam, M. Microbiology of pollen and bee bread: The yeasts. Apidologie 1979, 10, 43–53. [Google Scholar] [CrossRef]
- El Ghouizi, A.; Bakour, M.; Laaroussi, H.; Ousaaid, D.; El Menyiy, N.; Hano, C.; Lyoussi, B. Bee Pollen as Functional Food: Insights into Its Composition and Therapeutic Properties. Antioxidants 2023, 12, 557. [Google Scholar] [CrossRef] [PubMed]
- Denisow, B.; Denisow-Pietrzyk, M. Biological and Therapeutic Properties of Bee Pollen: A Review. J. Sci. Food Agric. 2016, 96, 4303–4309. [Google Scholar] [CrossRef] [PubMed]
- Fuenmayor, B.C.; Zuluaga, D.C.; Díaz, M.C.; De Quicazán, C.M.; Cosio, M.; Mannino, S. Evaluation of the Physicochemical and Functional Properties of Colombian Bee Pollen. Rev. MVZ Córdoba 2014, 19, 4003–4014. [Google Scholar] [CrossRef]
- Kieliszek, M.; Piwowarek, K.; Kot, A.M.; Błażejak, S.; Chlebowska-Śmigiel, A.; Wolska, I. Pollen and Bee Bread as New Health-Oriented Products: A Review. Trends Food Sci. Technol. 2018, 71, 170–180. [Google Scholar] [CrossRef]
- Thakur, M.; Nanda, V. Composition and Functionality of Bee Pollen: A Review. Trends Food Sci. Technol. 2020, 98, 82–106. [Google Scholar] [CrossRef]
- Wen, Y.; Wang, L.; Jin, Y.; Zhang, J.; Su, L.; Zhang, X.; Zhou, J.; Li, Y. The Microbial Community Dynamics during the Vitex Honey Ripening Process in the Honeycomb. Front. Microbiol. 2017, 8, 1649. [Google Scholar] [CrossRef]
- Rokop, Z.P.; Horton, M.A.; Newton, I.L.G. Interactions between Cooccurring Lactic Acid Bacteria in Honey Bee Hives. Appl. Environ. Microbiol. 2015, 81, 7261–7270. [Google Scholar] [CrossRef]
- Nowak, A.; Szczuka, D.; Górczyńska, A.; Motyl, I.; Kręgiel, D. Characterization of Apis Mellifera Gastrointestinal Microbiota and Lactic Acid Bacteria for Honeybee Protection—A Review. Cells 2021, 10, 701. [Google Scholar] [CrossRef]
- Anderson, K.E.; Carroll, M.J.; Sheehan, T.; Mott, B.M.; Maes, P.; Corby-Harris, V. Hive-stored Pollen of Honey Bees: Many Lines of Evidence Are Consistent with Pollen Preservation, Not Nutrient Conversion. Mol. Ecol. 2014, 23, 5904–5917. [Google Scholar] [CrossRef]
- Detry, R.; Simon-Delso, N.; Bruneau, E.; Daniel, H.-M. Specialisation of Yeast Genera in Different Phases of Bee Bread Maturation. Microorganisms 2020, 8, 1789. [Google Scholar] [CrossRef] [PubMed]
- Tsuruda, J.; Chakrabarti Basu, P.; Sagili, R. Honey Bee Nutrition. Vet. Clin. N. Am. Food Anim. Pract. 2021, 37, 505–519. [Google Scholar] [CrossRef] [PubMed]
- Giampieri, F.; Quiles, J.L.; Cianciosi, D.; Forbes-Hernández, T.Y.; Orantes-Bermejo, F.J.; Alvarez-Suarez, J.M.; Battino, M. Bee Products: An Emblematic Example of Underutilized Sources of Bioactive Compounds. J. Agric. Food Chem. 2022, 70, 6833–6848. [Google Scholar] [CrossRef] [PubMed]
- Stringini, M.; Comitini, F.; Taccari, M.; Ciani, M. Yeast Diversity in Crop-Growing Environments in Cameroon. Int. J. Food Microbiol. 2008, 127, 184–189. [Google Scholar] [CrossRef]
- Esteve-Zarzoso, B. Identification of Yeasts by RFLP Analysis of the 5.85 rRNA Gene and the Two Ribosomal Internal Transcribed Spacers. Int. J. Syst. Bacteriol. 1999, 49, 329–337. [Google Scholar] [CrossRef]
- Altschul, S. Gapped BLAST and PSI-BLAST: A New Generation of Protein Database Search Programs. Nucleic Acids Res. 1997, 25, 3389–3402. [Google Scholar] [CrossRef]
- Agarbati, A.; Moretti, L.; Canonico, L.; Ciani, M.; Comitini, F. Agro-Ecosystem of Honeybees as Source for Native Probiotic Yeasts. World J. Microbiol. Biotechnol. 2024, 40, 147. [Google Scholar] [CrossRef]
- Chen, B.; You, W.; Huang, J.; Yu, Y.; Chen, W. Isolation and Antioxidant Property of the Extracellular Polysaccharide from Rhodella reticulata. World J. Microbiol. Biotechnol. 2010, 26, 833–840. [Google Scholar] [CrossRef]
- Singleton, V.L.; Orthofer, R.; Lamuela-Raventós, R.M. Analysis of Total Phenols and Other Oxidation Substrates and Antioxidants by Means of Folin-Ciocalteu Reagent. In Methods in Enzymology; Oxidants and Antioxidants Part A; Academic Press: Cambridge, MA, USA, 1999; Volume 299, pp. 152–178. [Google Scholar]
- Bellachioma, L.; Rocchetti, G.; Morresi, C.; Martinelli, E.; Lucini, L.; Ferretti, G.; Damiani, E.; Bacchetti, T. Valorisation of Crocus Sativus Flower Parts for Herbal Infusions: Impact of Brewing Conditions on Phenolic Profiling, Antioxidant Capacity and Sensory Traits. Int. J. Food Sci. Technol. 2022, 57, 3838–3849. [Google Scholar] [CrossRef]
- Ganguly, S.; Kumar, Y.; Seal, T. Characterization of Secondary Metabolites in Different Parts of Ocimum gratissimum L. by in Vitro Antioxidant Activity and High-Performance Liquid Chromatography–Diode-Array Detector Analysis. Pharmacogn. Mag. 2021, 17, 209–215. [Google Scholar]
- Agarbati, A.; Canonico, L.; Marini, E.; Zannini, E.; Ciani, M.; Comitini, F. Potential Probiotic Yeasts Sourced from Natural Environmental and Spontaneous Processed Foods. Foods 2020, 9, 287. [Google Scholar] [CrossRef] [PubMed]
- Ogunremi, O.R.; Agrawal, R.; Sanni, A. Production and Characterization of Volatile Compounds and Phytase from Potentially Probiotic Yeasts Isolated from Traditional Fermented Cereal Foods in Nigeria. J. Genet. Eng. Biotechnol. 2020, 18, 16. [Google Scholar] [CrossRef] [PubMed]
- Kim, T.W.; Lei, X.G. An Improved Method for a Rapid Determination of Phytase Activity in Animal Feed1. J. Anim. Sci. 2005, 83, 1062–1067. [Google Scholar] [CrossRef]
- Perricone, M.; Bevilacqua, A.; Altieri, C.; Sinigaglia, M.; Corbo, M. Challenges for the Production of Probiotic Fruit Juices. Beverages 2015, 1, 95–103. [Google Scholar] [CrossRef]
- Speranza, B. Biofilm Formation by Potentially Probiotic Saccharomyces cerevisiae Strains. Food Microbiol. 2020, 87, 103393. [Google Scholar] [CrossRef]
- Pereira, W.A.; Mendonça, C.M.N.; Urquiza, A.V.; Marteinsson, V.Þ.; LeBlanc, J.G.; Cotter, P.D.; Villalobos, E.F.; Romero, J.; Oliveira, R.P.S. Use of Probiotic Bacteria and Bacteriocins as an Alternative to Antibiotics in Aquaculture. Microorganisms 2022, 10, 1705. [Google Scholar] [CrossRef]
- Shen, N.; Wang, T.; Gan, Q.; Liu, S.; Wang, L.; Jin, B. Plant Flavonoids: Classification, Distribution, Biosynthesis, and Antioxidant Activity. Food Chem. 2022, 383, 132531. [Google Scholar] [CrossRef]
- Moslehi-Jenabian, S.; Pedersen, L.L.; Jespersen, L. Beneficial Effects of Probiotic and Food Borne Yeasts on Human Health. Nutrients 2010, 2, 449–473. [Google Scholar] [CrossRef]
- Tomás, A.; Falcão, S.I.; Russo-Almeida, P.; Vilas-Boas, M. Potentialities of Beebread as a Food Supplement and Source of Nutraceuticals: Botanical Origin, Nutritional Composition and Antioxidant Activity. J. Apic. Res. 2017, 56, 219–230. [Google Scholar] [CrossRef]
- Baky, M.H.; Abouelela, M.B.; Wang, K.; Farag, M.A. Bee Pollen and Bread as a Super-Food: A Comparative Review of Their Metabolome Composition and Quality Assessment in the Context of Best Recovery Conditions. Molecules 2023, 28, 715. [Google Scholar] [CrossRef]
- Barta, D.G.; Cornea-Cipcigan, M.; Margaoan, R.; Vodnar, D.C. Biotechnological Processes Simulating the Natural Fermentation Process of Bee Bread and Therapeutic Properties—An Overview. Front. Nutr. 2022, 9, 871896. [Google Scholar] [CrossRef] [PubMed]
- Agarbati, A.; Gattucci, S.; Canonico, L.; Ciani, M.; Comitini, F. Yeast Communities Related to Honeybees: Occurrence and Distribution in Flowers, Gut Mycobiota, and Bee Products. Appl. Microbiol. Biotechnol. 2024, 108, 175. [Google Scholar] [CrossRef] [PubMed]
- Kogan, H.V.; Elikan, A.B.; Glaser, K.F.; Bergmann, J.M.; Raymond, L.M.; Prado-Irwin, S.R.; Snow, J.W. Colonization of Honey Bee Digestive Tracts by Environmental Yeast Lachancea thermotolerans Is Naturally Occurring, Temperature Dependent, and Impacts the Microbiome of Newly Emerged Bees. Microbiol. Spectr. 2023, 11, e0519422. [Google Scholar] [CrossRef] [PubMed]
- Giger-Reverdin, S.; Bezault, N.; Sauvant, D.; Bertin, G. Effects of a Probiotic Yeast in Lactating ruminants: Interaction with Dietary Nitrogen Level. Anim. Feed Sci. Technol. 1996, 63, 149–162. [Google Scholar] [CrossRef]
- Busscher, H.J. Effect of Probiotic Bacteria on Prevalence of Yeasts in Oropharyngeal Bio®lms on Silicone Rubber Voice Prostheses in Vitro. J. Med. Microbiol. 2000, 49, 713–718. [Google Scholar]
- Gusils, C.; Chaia, A.P.; González, S.; Oliver, G. Lactobacilli Isolated from Chicken Intestines: Potential Use as Probiotics. J. Food Prot. 1999, 62, 252–256. [Google Scholar] [CrossRef]
- Jakobsen, M.; Narvhus, J. Yeasts and Their Possible Beneficial and Negative Effects on the Quality of Dairy Products. Int. Dairy J. 1996, 6, 755–768. [Google Scholar] [CrossRef]
- Pozo, M.I.; Van Kemenade, G.; Van Oystaeyen, A.; Aledón-Catalá, T.; Benavente, A.; Van Den Ende, W.; Wäckers, F.; Jacquemyn, H. The Impact of Yeast Presence in Nectar on Bumble Bee Behavior and Fitness. Ecol. Monogr. 2020, 90, e01393. [Google Scholar] [CrossRef]
- Rosa, C.; Lachance, M.; Silva, J.; Teixeira, A.; Marini, M.; Antonini, Y.; Martins, R. Yeast Communities Associated with Stingless Bees. FEMS Yeast Res. 2003, 4, 271–275. [Google Scholar] [CrossRef]
- Ries, E.F.; Macedo, G.A. Progressive Screening of Thermostable Yeasts for Phytase Production. Food Sci. Biotechnol. 2009, 18, 655–660. [Google Scholar]
- Gil-Rodríguez, A.M.; Carrascosa, A.V.; Requena, T. Yeasts in Foods and Beverages: In Vitro Characterisation of Probiotic Traits. LWT—Food Sci. Technol. 2015, 64, 1156–1162. [Google Scholar] [CrossRef]
- Ogunremi, O.R.; Sanni, A.I.; Agrawal, R. Probiotic Potentials of Yeasts Isolated from Some Cereal-Based Nigerian Traditional Fermented Food Products. J. Appl. Microbiol. 2015, 119, 797–808. [Google Scholar] [CrossRef] [PubMed]
- Chen, H.; Shi, X.; Cen, L.; Zhang, L.; Dai, Y.; Qiu, S.; Zeng, X.; Wei, C. Effect of Yeast Fermentation on the Physicochemical Properties and Bioactivities of Polysaccharides of Dendrobium Officinale. Foods 2023, 12, 150. [Google Scholar] [CrossRef]
- Freimoser, F.M.; Rueda-Mejia, M.P.; Tilocca, B.; Migheli, Q. Biocontrol Yeasts: Mechanisms and Applications. World J. Microbiol. Biotechnol. 2019, 35, 154. [Google Scholar] [CrossRef] [PubMed]
- Diaz De Rienzo, M.A.; Stevenson, P.S.; Marchant, R.; Banat, I.M. Effect of Biosurfactants on Pseudomonas aeruginosa and Staphylococcus aureus Biofilms in a BioFlux Channel. Appl. Microbiol. Biotechnol. 2016, 100, 5773–5779. [Google Scholar] [CrossRef]
- Valotteau, C.; Banat, I.M.; Mitchell, C.A.; Lydon, H.; Marchant, R.; Babonneau, F.; Pradier, C.M.; Baccile, N.; Humblot, V. Antibacterial Properties of Sophorolipid-Modified Gold Surfaces against Gram Positive and Gram Negative Pathogens. Colloids Surf. B Biointerfaces 2017, 157, 325–334. [Google Scholar] [CrossRef]
- de O Caretta, T.; A I Silveira, V.; Andrade, G.; Macedo, F.; Celligoi, M.A.P.C. Antimicrobial Activity of Sophorolipids Produced by Starmerella bombicola against Phytopathogens from Cherry Tomato. J. Sci. Food Agric. 2021, 102, 1245–1254. [Google Scholar] [CrossRef]
- Nissar, J.; Ahad, T.; Naik, H.; Hussain, S. A Review Phytic Acid: As Antinutrient or Nutraceutical. J. Pharmacogn. Phytochem. 2017, 6, 1554–1560. [Google Scholar]
), molds (
), and yeasts. The latter is divided into osmophilic (
) and non-osmophilic (
) yeasts.
), molds (
), and yeasts. The latter is divided into osmophilic (
) and non-osmophilic (
) yeasts.

| Source | Sample Code | Yeast Species Identification | GenBank Accession Number | Grouping |
|---|---|---|---|---|
| Bee pollen | 1BP | Cryptococcus aureus | PQ571343 | Group 1 |
| Bee pollen | 3BP | Starmerella spp. | PQ571344 | Group 2 |
| Bee pollen | 9BP | Bullera alba | PQ571345 | Group 3 |
| Bee pollen | 15BP | Starmerella spp. | PQ571346 | Group 4 |
| Bee pollen | 17BP | Microstroma album | PQ571347 | Group 5 |
| Fresh bee bread | 52BB | Starmerella magnoliae | PQ571351 | Group 6 |
| Fresh bee bread | 54BB | Zygosaccharomyces pseudorouxii | PQ571352 | Group 7 |
| Fresh bee bread | 55BB | Metschnikowia rancensis | PQ571353 | Group 8 |
| Fresh bee bread | 65BB | Zygosaccharomyces siamensis | PQ571354 | Group 9 |
| Fresh bee bread | 67BB | Starmerella magnoliae | PQ571355 | Group 10 |
| Aged bee bread | 18BB | Starmerella spp. | PQ571348 | Group 11 |
| Aged bee bread | 20BB | Aureobasidium pullulans | PQ571349 | Group 12 |
| Aged bee bread | 88BB | Metschnikowia viticola | PQ571356 | Group 13 |
| Aged bee bread | 91BB | Kodamaea ohmeri | PQ571357 | Group 14 |
| Aged bee bread | 93BB | Starmerella spp. | PQ571358 | Group 15 |
| Aged bee bread | 94BB | Moniliella spp. | PQ571359 | Group 16 |
| Aged bee bread | 21H | Aureobasidium pullulans | PQ571350 | Group 17 |
| Sensitive Strains | 3BP | 15BP | 52BB | 54BB | 55BB | 65BB | 67BB | 18BB | 20BB | 88BB | 91BB | 93BB | 21H | Codex® | |
|---|---|---|---|---|---|---|---|---|---|---|---|---|---|---|---|
| Pathogenic bacteria inhibition (mm) | S. aureus | 0 | 0 | 0 | 0 | 0 | 0 | 0 | 0 | 0 | 0 | 0 | 12 | 0 | 0 |
| S. enterica | 0 | 0 | 12 | 0 | 0 | 0 | 15 | 13 | 0 | 11 | 0 | 0 | 0 | 15 | |
| E. coli | 0 | 0 | 0 | 0 | 0 | 0 | 13 | 17 | 0 | 13 | 0 | 0 | 0 | 17 | |
| L. monocytogenes | 0 | 15 | 0 | 0 | 0 | 12 | 18 | 21 | 0 | 20 | 0 | 0 | 0 | 22 | |
| killer activity (mm) | S. cerevisiae DBVPG 6500 | 0 | 0 | 0 | 0 | 0 | 0 | 0 | 0 | 0 | 0 | 0 | 0 | 0 | 0 |
| B. bruxellensis DBVPG 6706 | 0 | 0 | 0 | 0 | 0 | 0 | 0 | 0 | 0 | 0 | 0 | 0 | 0 | 0 | |
| Mold reduction (%) | P. expansum | 3 | 6 | 0 | 0 | 0 | 3 | 7 | 15 | 13 | 6 | 3 | 0 | 16 | 16 |
| A. carbonarius | 11 | 15 | 8 | 5 | 8 | 8 | 11 | 14 | 32 | 11 | 16 | 13 | 26 | 18 | |
| P. digitatum | 13 | 10 | 11 | 26 | 18 | 13 | 14 | 15 | 24 | 10 | 16 | 5 | 22 | 11 | |
| C. fulvum | 13 | 15 | 12 | 12 | 7 | 13 | 15 | 15 | 18 | 15 | 18 | 17 | 18 | 11 | |
| B. cinerea | 18 | 55 | 14 | 18 | 10 | 10 | 70 | 74 | 25 | 13 | 10 | 6 | 23 | 72 |
| Probiotic Features | 3BP | 15BP | 18BB | 20BB | 21H | 52BB | 54BB | 55BB | 65BB | 67BB | 88BB | 91BB | 93BB | Codex® |
|---|---|---|---|---|---|---|---|---|---|---|---|---|---|---|
| 37 °C pH 2.0 (Log CFU/mL) | 5.74 ± 0.04 | 5.18 ± 0.15 | 5.73 ± 0.10 | 0 | 0 | 5.88 ± 0.03 | 0 | 5.24 ± 0.00 | 0 | 5.28 ± 0.03 | 4.68 ± 0.38 | 5.37 ± 0.17 | 6.44 ± 0.09 | 5.24 ± 0.26 |
| Pepsin (Log CFU/mL) | 6.10 ± 0.07 | 5.48 ± 0.15 | 5.67 ± 0.03 | 0 | 0 | 5.89 ± 0.03 | 0 | 5.47 ± 0.01 | 0 | 5.49 ± 0.10 | 4.53 ± 0.26 | 5.32 ± 0.31 | 5.93 ± 0.19 | 5.47 ± 0.25 |
| Bile salts (Log CFU/mL) | 5.74 ± 0.04 | 5.82 ± 0.08 | 6.00 ± 0.14 | 0 | 0 | 5.67 ± 0.04 | 0 | 5.56 ± 0.23 | 0 | 5.36 ± 0.33 | 4.28 ± 0.03 | 5.52 ± 0.13 | 4.20 ± 0.15 | 4.20 ± 0.15 |
| Hydrophobicity (%) | 5.32 ± 0.78 | 59.86 ± 4.03 | 50.00 ± 4.17 | 6.21 ± 1.12 | 12.40 ± 0.80 | 50.71 ± 1.94 | 61.34 ± 4.89 | 5.09 ± 1.33 | 11.71 ± 2.48 | 62.30 ± 0.18 | ||||
| Auto-aggregation (%) | 20.7 ± 0.03 | 74.56 ± 0.01 | 54.43 ± 0.02 | 35.54 ± 0.05 | 72.98 ± 0.02 | 37.51 ± 0.04 | 88.18 ± 0.04 | 81.00 ± 0.01 | 55.37 ± 0.03 | 91.99 ± 0.02 | ||||
| Caco-2 adhesion (%) | 36.43 ± 0.17 | 61.46 ± 0.02 | 89.92 ± 0.58 | 47.42 ± 0.00 | 77.33 ± 0.06 | 63.76 ± 0.15 | 84.99 ± 0.06 | 26.50 ± 0.01 | 31.70 ± 0.03 | 90.28 ± 0.01 | ||||
| Biofilm formation (%) | 0.02 ± 0.00 | 0.62 ± 0.06 | 12.69 ± 0.01 | 1.72 ± 0.03 | 0.40 ± 0.03 | 0.26 ± 0.02 | 0.02 ± 0.03 | 0.92 ± 0.02 | 0.03 ± 0.00 | 0.03 ± 0.03 |
Disclaimer/Publisher’s Note: The statements, opinions and data contained in all publications are solely those of the individual author(s) and contributor(s) and not of MDPI and/or the editor(s). MDPI and/or the editor(s) disclaim responsibility for any injury to people or property resulting from any ideas, methods, instructions or products referred to in the content. |
© 2025 by the authors. Licensee MDPI, Basel, Switzerland. This article is an open access article distributed under the terms and conditions of the Creative Commons Attribution (CC BY) license (https://creativecommons.org/licenses/by/4.0/).
Share and Cite
Agarbati, A.; Canonico, L.; Gattucci, S.; Ciani, M.; Comitini, F. From Pollen to Bee Bread: A Reservoir of Functional Yeasts. Fermentation 2025, 11, 290. https://doi.org/10.3390/fermentation11050290
Agarbati A, Canonico L, Gattucci S, Ciani M, Comitini F. From Pollen to Bee Bread: A Reservoir of Functional Yeasts. Fermentation. 2025; 11(5):290. https://doi.org/10.3390/fermentation11050290
Chicago/Turabian StyleAgarbati, Alice, Laura Canonico, Silvia Gattucci, Maurizio Ciani, and Francesca Comitini. 2025. "From Pollen to Bee Bread: A Reservoir of Functional Yeasts" Fermentation 11, no. 5: 290. https://doi.org/10.3390/fermentation11050290
APA StyleAgarbati, A., Canonico, L., Gattucci, S., Ciani, M., & Comitini, F. (2025). From Pollen to Bee Bread: A Reservoir of Functional Yeasts. Fermentation, 11(5), 290. https://doi.org/10.3390/fermentation11050290

